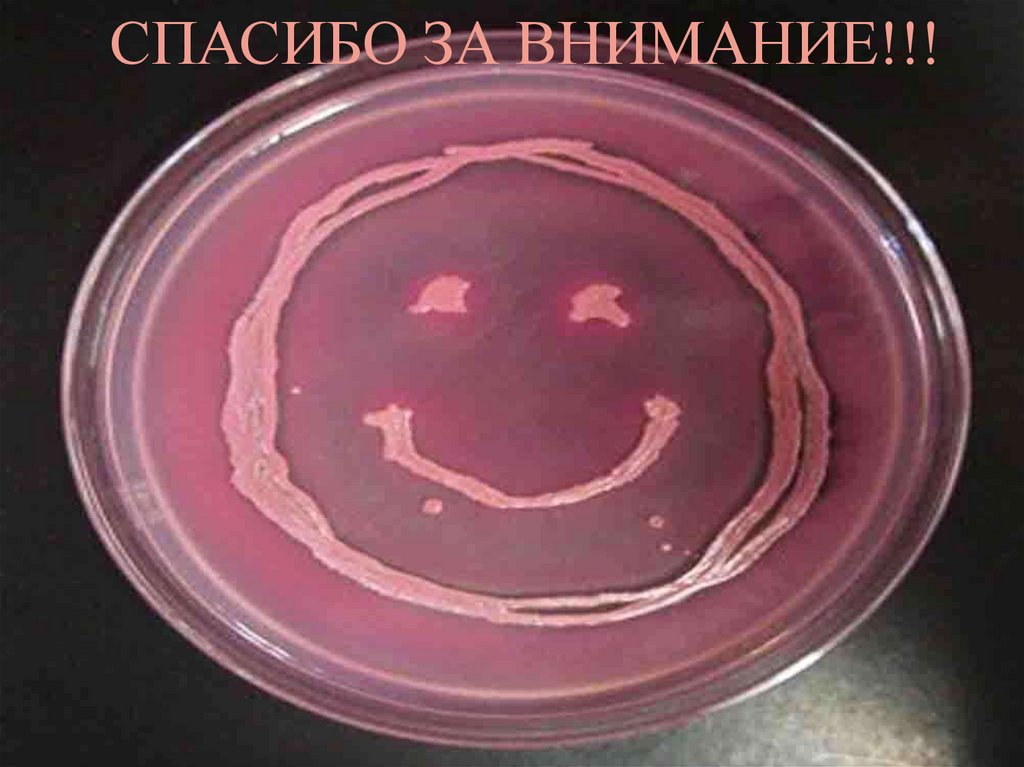

Похожие презентации:
lektsia_1
1. Лекция 1. Классификация микроорганизмов. Типы взаимоотношений микро- и макроорганизмов. Организация микробиологической
ЛЕКЦИЯ 1. КЛАССИФИКАЦИЯМИКРООРГАНИЗМОВ.
ТИПЫ ВЗАИМООТНОШЕНИЙ МИКРО- И
МАКРООРГАНИЗМОВ.
ОРГАНИЗАЦИЯ
МИКРОБИОЛОГИЧЕСКОЙ
ЛАБОРАТОРНОЙ СЛУЖБЫ.
2. Предмет и задачи
ПРЕДМЕТ И ЗАДАЧИБактериология - раздел микробиологии, изучающий
строение, физиологию, биохимию, генетику, систематику
бактерий, их распространение и роль в природе.
Микология – наука о грибах изучение эукариотные,
гетеротрофные организмы, отличающиеся
дифференцированными тканями, клеточными стенками,
а также спорами, служащими для распространения.
Одна из перспективных задач микологии – это
повышение чувствительности и специфичности
молекулярно-генетических методов диагностики микозов.
Вирусология - наука о вирусах — микроскопических
надмолекулярных созданиях природы, которые являются
своеобразной паразитической формой жизни.
Задачами современной вирусологии является
исследование физиологии вирусов, а также их генетики и
эволюции.
3.
Паразитология - наука, изучающая паразитов, ихвзаимоотношения с хозяевами, переносчиками и окружающей
средой, а также вызываемые ими болезнями и меры борьбы с
ними.
Основные задачи медицинской паразитологии:
§ разработка лечения и диагностики паразитарных заболеваний
на основе знания негативного воздействия паразитов, методов
борьбы и профилактики с переносчиками и паразитами;
§ создание системы, обеспечивающей ликвидацию и
профилактику паразитарных заболеваний;
§ изучение строения паразитов на разных стадиях развития для
определения их вида;
§ изучения цепочки «паразит-хозяин»;
§ изучение систематики объектов паразитологии;
§ изучение цикла развития переносчиков и паразитов,
установление путем циркуляции паразитов и способы их
проникновения в организм человека.
4. Основные понятия
ОСНОВНЫЕ ПОНЯТИЯКлассификация- распределение (объединение) организмов в
соответствии с их общими свойствами (сходными
генотипическими и фенотипическими признаками) по
различным таксонам.
Систематикараспределение
микроорганизмов
в
соответствии с их происхождением и биологическим
сходством.
Таксономия- наука о методах и принципах распределения
(классификации) организмов в соответствии с их иерархией. В
основу
таксономии
микроорганизмов
положены
их
морфологические, физиологические,
биохимические
и
молекулярно-биологические свойства. Различают следующие
таксономические категории: царство, подцарство, отдел,
класс, порядок, семейство, род, вид, подвид и др.
5.
МИКРОБЫДоклеточные
формы (вирусы)
Клеточные формы
(бактерии,
архебактерии, грибы,
простейшие)
6. Различают 3 домена (или «империи»)
РАЗЛИЧАЮТ 3 ДОМЕНА(ИЛИ «ИМПЕРИИ»)
Домен
«Bacteria»
—
прокариоты,
представленные
настоящими бактериями (эубактериями);
Домен
«Archaea» — прокариоты, представленные
архебактериями. Они не имеют оформленного ядра и
организованных органелл.
Домен «Eukarya» — эукариоты, клетки которых имеют ядро
с ядерной оболочкой и ядрышком, а цитоплазма состоит из
высоко-организованных органелл — митохондрий, аппарата
Гольджи и др. Домен
«Eukarya» включает: царство Fungi (грибы); царство животных
Animalia (включает прстейшие – подцарство Protozoa); царство
растений Plante. Домены включают царства, типы, классы,
порядки, семейства, роды, виды.
7. ОСНОВНЫЕ ТАКСОНОМИЧЕСКИЕ КАТЕГОРИИ
Вид (species) — это совокупность микроорганизмов,имеющих общее эволюционное происхождение, близкий
генотип
и
максимально
близкие
фенотипические
характеристики.
Чистая
культура – это совокупность однородных
микроорганимов, выделенных на питательной среде,
характеризующихся
сходными
морфологическими,
тинкториальными
(отношение
к
красителям),
культуральными,
биохимическими
и
антигенными
свойствами.
Штамм
– это чистая культура микроорганизмов,
выделенных из определенного источника и отличающихся от
других представителей вида.
Штамм — более узкое понятие, чем вид или подвид.
8. КОЛОНИЯ - ВИДИМАЯ ИЗОЛИРОВАННАЯ СТРУКТУРА ПРИ РАЗМНОЖЕНИИ БАКТЕРИЙ НА ПЛОТНЫХ ПИТАТЕЛЬНЫХ СРЕДАХ, МОЖЕТ РАЗВИВАТЬСЯ ИЗ ОДНОЙ
ИЛИ НЕСКОЛЬКИХРОДИТЕЛЬСКИХ КЛЕТОК.
КЛОН - СОВОКУПНОСТЬ ПОТОМКОВ,
ВЫРАЩЕННЫХ ИЗ ЕДИНСТВЕННОЙ МИКРОБНОЙ
КЛЕТКИ.
ДЛЯ ОБОЗНАЧЕНИЯ ВИДОВ БАКТЕРИЙ
ИСПОЛЬЗУЮТ БИНАРНУЮ ЛАТИНСКУЮ
НОМЕНКЛАТУРУ (Т.Е. СОСТОИТ ИЗ ДВУХ СЛОВ)
РОД/ВИД, СОСТОЯЩУЮ ИЗ НАЗВАНИЯ РОДА
(ПИШЕТСЯ С ЗАГЛАВНОЙ БУКВЫ) И ВИДА (СО
СТРОЧНОЙ БУКВЫ)
ПРИМЕРЫ - SHIGELLA FLEXNERI,
RICKETTSIA SIBIRICA,
9.
10.
Симбиоз - сожительство (от.греч.сим - вместе, биос жизнь) - форма взаимоотношения, из которых обапартнера или хотя бы один извлекают пользу.
Примеры симбиоза
Зелёная гидра
с
одноклеточны
ми
водорослями
Форму
Сожительство
рака –
отшельника и
11.
Взаимоотношения припитании муравьёв
сахаристыми
выделениями гусениц
бабочки – голубянки
(муравьи защищают
этих гусениц от
хищников и паразитов,
а гусеницы перед
окукливанием
зарываются в
муравейник).
Термиты,
пищеварительный тракт
которых служит
приютом для
жгутиковых или
бактерий. Благодаря
симбиозу, термиты в
состоянии переварить
древесину, а
микроорганизмы
получают убежище, вне
которого они
12. По степени соединения организмов и по их пищевой зависимости друг от друга различают несколько типов симбиоза: МУТУАЛИЗМ,
ПО СТЕПЕНИ СОЕДИНЕНИЯ ОРГАНИЗМОВ И ПО ИХ ПИЩЕВОЙЗАВИСИМОСТИ ДРУГ ОТ ДРУГА РАЗЛИЧАЮТ НЕСКОЛЬКО
ТИПОВ СИМБИОЗА: МУТУАЛИЗМ, КОММЕНСАЛИЗМ,
ПРОТОКООПЕРАЦИЯ.
Мутуализм — симбиотические взаимоотношения, когда оба
сожительствующих вида извлекают взаимную пользу.
Примеры:
Взаимоотношени
я воловьих птиц
и носорогов
(птицы кормятся
насекомымипаразитами на
коже носорога, а
их взлёт служит
ему сигналом об
опасности).
Взаимоотношения
узкоспециализиро
ванных к
опылению
растений (инжир,
дурман,
орхидейные) с
опыляющими их
видами
насекомых.
13.
Комменсализм (дословно - "питание вместе за одним столом") —взаимоотношения видов, при которых один из партнеров получает пользу, не
нанося ущерб другому.
Типы взаимоотношений конкретной пары могут
изменяться в зависимости от внешних условий
или
стадий
жизни
взаимодействующих
организмов. В природе во взаимоотношения
оказывается вовлечённой не пара, а гораздо
большее число. Межвидовые отношения в
природе бесконечно разнообразны.
Отношения типа комменсализма играют
важную роль в природе, так как способствуют
более тесному сожительству видов, более
полному освоению среды и использованию
пищевых ресурсов.
14. Проявления комменсализма разнообразны, поэтому в нём выделяют ряд вариантов:
ПРОЯВЛЕНИЯ КОММЕНСАЛИЗМАРАЗНООБРАЗНЫ, ПОЭТОМУ В НЁМ
ВЫДЕЛЯЮТ РЯД ВАРИАНТОВ:
«Нахлебничество»
— потребление остатков пищи
хозяина. Таковы, например, взаимоотношения львов и
гиен, подбирающих остатки недоеденной пищи, или
акул с рыбами-прилипалами.
15. «СОТРАПЕЗНИЧЕСТВО» — ПОТРЕБЛЕНИЕ РАЗНЫХ ВЕЩЕСТВ ИЛИ ЧАСТЕЙ ОДНОЙ И ТОЙ ЖЕ ПИЩИ. НАПРИМЕР: ВЗАИМООТНОШЕНИЯ МЕЖДУ РАЗЛИЧНЫМИ
ВИДАМИ ПОЧВЕННЫХ,ПЕРЕРАБАТЫВАЮЩИХ РАЗНЫЕ ОРГАНИЧЕСКИЕ
ВЕЩЕСТВА ИЗ ПЕРЕГНИВШИХ РАСТИТЕЛЬНЫХ
ОСТАТКОВ, И ВЫСШИМИ РАСТЕНИЯМИ, КОТОРЫЕ
ПОТРЕБЛЯЮТ ОБРАЗОВАВШИЕСЯ ПРИ ЭТОМ
МИНЕРАЛЬНЫЕ СОЛИ.
«КВАРТИРАНСТВО» — ИСПОЛЬЗОВАНИЕ ОДНИМИ
ВИДАМИ ДРУГИХ (ИХ ТЕЛ
ИЛИ ИХ ЖИЛИЩ)
В КАЧЕСТВЕ УБЕЖИЩА
ИЛИ ЖИЛИЩА.
ТАКОЙ ТИП
ВЗАИМООТНОШЕНИЙ
ШИРОКО
РАСПРОСТРАНЁН
16. Паразитизм — это форма взаимоотношений между видами, при которой организмы одного вида (паразита, потребителя) живут за счет
ПАРАЗИТИЗМ — ЭТО ФОРМА ВЗАИМООТНОШЕНИЙ МЕЖДУВИДАМИ, ПРИ КОТОРОЙ ОРГАНИЗМЫ ОДНОГО ВИДА (ПАРАЗИТА,
ПОТРЕБИТЕЛЯ) ЖИВУТ ЗА СЧЕТ ПИТАТЕЛЬНЫХ ВЕЩЕСТВ ИЛИ
ТКАНЕЙ ОРГАНИЗМА ДРУГОГО ВИДА (ХОЗЯИНА) В ТЕЧЕНИЕ
ОПРЕДЕЛЁННОГО ВРЕМЕНИ. ХОЗЯЕВАМИ, КАК И ПАРАЗИТАМИ,
МОГУТ БЫТЬ И ЖИВОТНЫЕ, И РАСТЕНИЯ.
Паразитизм близок к хищничеству, однако в отличие от
настоящего хищника паразит не убивает хозяина сразу.
Обычно он использует живого хозяина как место своего
временного или постоянного проживания. Паразит изнуряет,
но не губит хозяина, поскольку последний обеспечивает его
существование.
17. Классификация микроорганизмов по степени их биологической опасности.
КЛАССИФИКАЦИЯМИКРООРГАНИЗМОВ ПО СТЕПЕНИ
ИХ БИОЛОГИЧЕСКОЙ
ОПАСНОСТИ.
Работа с микроорганизмами регламентируются
правилами и требованиями, направленными на
обеспечение личной и общественной безопасности,
защиту окружающей среды при работе с
биологическими агентами:
СП 1.3.2322-08 – РЕГЛАМЕНТИРУЕТ РАБОТУ С
МИКРООРГАНИЗМАМИ 3-4 ГРУППЫ ПАТОГЕННОСТИ;
СП 1.3.1265-03 – РЕГЛАМЕНТИРУЕТ
РАБОТУ С
МИКРООРГАНИЗМАМИ 1-2-ГРУППЫ ПАТОГЕННОСТИ.
18. По степени биологической опасности все микроорганизмы делятся на 4 группы:
ПО СТЕПЕНИ БИОЛОГИЧЕСКОЙ ОПАСНОСТИВСЕ МИКРООРГАНИЗМЫ ДЕЛЯТСЯ НА 4
ГРУППЫ:
1-я – возбудители особо опасных инфекций, например, чумы,
натуральной оспы, желтой лихорадки.
2-я – возбудители высококонтагиозных эпидемических
заболеваний человека, например, сибирской язвы,
бруцеллеза, малярии, сыпного тифа.
3-я – возбудители инфекционных болезней, выделяемых в
самостоятельные нозологические группы, например,
брюшного тифа, шигеллеза, дифтерии.
4-я – условно-патогенные микроорганизмы, возбудители
оппортунистических инфекций, например, клебсиеллы,
протей.
19. Номенклатура микробиологических лабораторий
МИКРОБИОЛОГИЧЕСКИХЛАБОРАТОРИЙ
1.
Диагностические
(клинико– диагностические и
санитарно- эпидемиологические) лаборатории:
проводят микробиологическую диагностику
инфекционных заболеваний: выделение и
идентификацию возбудителя, выявление
иммунологических изменений у больного. На основании
результатов лабораторных исследований составляется
рациональная схема терапии.
выполняют бактериологические, вирусологические,
микологические, серологические исследования
материала от здоровых людей, работающих в системе
здравоохранения, торговли, общественного питания,
образования, сельского хозяйства и пр.
Научно-исследовательские
микробиологические лаборатории: изучение
2.
физиолого-биохимических и генетических особенностей
микроорганизмов, механизмов и способов получения БАВ и
т.д.
20.
3. Производственнаямикробиологическая лаборатория
(фармацевтического производства):
осуществляет микробиологический контроль сырья,
вспомогательных материалов, готовой продукции,
санитарно-гигиенического состояния производственных
помещений, технологического оборудования, инвентаря,
тары, рук, одежды работающих, а также разработку и
валидацию методик определения микробиологических
показателей, работу с культурами-продуцентами БАВ и
т.д.
4. Специализированные лаборатории,
обеспечивающие безопасность персонала и
невозможность «утечки» патогенных
микроорганизмов за пределы лаборатории:
работа с возбудителями особо опасных инфекций, таких
как чума, холера, желтая лихорадка и др..
21. Оснащение базовой микробиологической лаборатории
ОСНАЩЕНИЕ БАЗОВОЙМИКРОБИОЛОГИЧЕСКОЙ
ЛАБОРАТОРИИ
Микробиологическая лаборатория
располагается в отдельно стоящем здании или в
изолированной части здания.
На окнах цокольного и первого этажей должны
быть установлены металлические решетки.
Также в лаборатории должна быть установлена
охранная сигнализация.
Лаборатория должна иметь 2 входа: один – для
сотрудников, другой – для доставки материала
на исследование (допускается получение
материала через передаточное окно)
Микробиологические лаборатории должны
иметь необходимый набор помещений в
соответствии с производственной мощностью и
номенклатурой выполняемых исследований.
22.
В лабораториях должны быть проведеныводопровод, электричество, отопление и
вентиляция.
В системе водоснабжения должны быть
предусмотрены раздельные сети подачи воды
для лабораторных исследований и бытовых
нужд (сеть питьевой воды).
Вентиляция должна быть приточно-вытяжной.
При необходимости вентиляцию следует
оснастить фильтрами тонкой очистки воздуха.
Помещения должны иметь естественное и
искусственное освещение.
Каждая лаборатория должна иметь «чистую» и
«грязную» зоны.
23. Грязная зона микробиологических лабораторий
ГРЯЗНАЯ ЗОНАМИКРОБИОЛОГИЧЕСКИХ
ЛАБОРАТОРИЙ
Помещения для приёма и регистрации
материала.
Боксы и комнаты для проведения
микробиологических исследований.
Помещения для проведения серологических
исследований.
Комната для проведения люминесцентной
микроскопии.
Термостатная.
Автоклавная для обеззараживания
материала.
Окна и двери всех помещений должны
герметично закрываться.
24.
Приточно-вытяжная вентиляция «грязной»зоны должна быть оборудована фильтрами
тонкой очистки выбрасываемого воздуха.
Помещения для проведения работ с живыми
ПБА должны быть оборудованы
бактерицидными лампами.
Обязательна маркировка автоклавов, столов,
стеллажей для чистого и инфицированного
материала.
Покрытие лабораторной мебели, поверхности
пола, стен и потолка должны быть гладкими и
устойчивыми к действию моющих и
дезинфицирующих средств.
25. Чистая зона микробиологических лабораторий
ЧИСТАЯ ЗОНАМИКРОБИОЛОГИЧЕСКИХ
ЛАБОРАТОРИЙ
гардероб для верхней одежды
комнаты отдыха
комнату для работы с документацией
комнату для надевания рабочей одежды
подсобные помещения, душевую, туалет
помещения для предварительных работ
(препараторская, моечная)
комната приготовления и разлива питательных сред
и др.)
стерилизационную
помещения с холодильниками для хранения
питательных сред и диагностических препаратов
В «чистой» зоне возможна работа с неживыми ПБА
(серологические и биохимические исследования)
26. Минимальный набор помещений в лаборатории
МИНИМАЛЬНЫЙ НАБОРПОМЕЩЕНИЙ В ЛАБОРАТОРИИ
1)
2)
3)
4)
5)
Собственно лабораторные комнаты
Помещение для приготовления
питательных сред (газовая или
электрическая плита, дистиллятор,
холодильник и шкафы для хранения
сухих питательных сред)
Моечная (ванны или раковины для
мытья лабораторной посуды, моющие
средства, столы)
Стерилизационная
Виварий (только в больших
лабораториях)
27. Правила работы в микробиологической лаборатории
ПРАВИЛА РАБОТЫ ВМИКРОБИОЛОГИЧЕСКОЙ ЛАБОРАТОРИИ
1.
2.
3.
4.
5.
6.
Работу в лаборатории осуществляют только в
халате и шапочке
Не допускаются излишние разговоры и
перемещения по лаборатории
Каждый сотрудник имеет постоянное рабочее
место, где выполняет основную работу.
Запрещаются прием пищи и курение.
При работе с заразным материалом
необходимо пользоваться инструментарием
(бактериальные
петлями,
пинцетами,
шпателями и т.д..)
Весь контаминированный материал, посуда,
инструменты должны быть обязательно
обеззаражены.
28.
7.8.
9.
10.
11.
12.
При работе с пипетками необходимо пользоваться
резиновыми грушами.
Работа с микроорганизмами производят только вблизи
зажженной горелки, при этом обязательно обжигают
края пробирок, петли, шпатели и т.д..
Зажигают горелку спичкой или зажигалкой, гасят –
накрывая колпачком горелки.
Нельзя переносить зажженную горелку с места на место,
необходимо сначала потушить горелку, а на новом месте
зажечь ее вновь.
Если вдруг заразный материал попал на окружающие
предметы, необходимо провести обработку этого участка
дезинфицирующим раствором.
После работы необходимо протереть иммерсионный
объектив, привести микроскоп в нерабочее положение и
обязательно вымыть руки с мылом.
29. Техника безопасности при работе с инфицированным материалом.
ТЕХНИКА БЕЗОПАСНОСТИ ПРИ РАБОТЕ СИНФИЦИРОВАННЫМ МАТЕРИАЛОМ.
NB!!! Весь материал, поступающий в лабораторию на
исследование, должен рассматриваться как
инфицированный!
1. В лаборатории необходимо находиться в медицинском халате с
длинными рукавами, колпачке и сменной обуви. Личные вещи
следует хранить в специально отведенном месте.
2. В лаборатории категорически запрещается:
- принимать пищу;
- курить.
3. С инфицированным материалом необходимо работать только
с помощью инструментов (пинцеты, петли и т.д.)
4. Запрещается прикасаться руками к исследуемому материалу
и конденсату в засеянных чашках, держать чашки и пробирки с
инфицированным материалом открытыми.
30.
5. Пробирки с заразным материалом должны находиться вштативах, бактериологические петли и другой инструмент - в
специальных стаканчиках или штативах.
6. Забор инфекционного материала в пипетки осуществляется
только с помощью резиновой груши, насасывать ртом и
переливать растворы из сосуда в сосуд через край запрещается.
7. При посеве материала пробирки, чашки и т.д. обязательно
подписываются с указанием номера культуры и даты посева.
8. По окончании работы запрещается оставлять на рабочем
месте нефиксированные мазки и лабораторную посуду с
инфицированным материалом.
9. После использования лабораторная посуда с отработанным
материалом помещается в баки с крышками, после чего
производится его убивка автоклавированием.
31.
10. В бактериологической лаборатории должны находитьсяследующие дез.растворы:
а) для замачивания использованных стекол, пипеток, шпателей и
т.д.
б) для обработки рук;
в) для обработки поверхности рабочих столов.
11. После окончания занятия каждый студент должен провести
дезинфекцию рабочего места, после чего вымыть руки с мылом.

Биология
Биология








